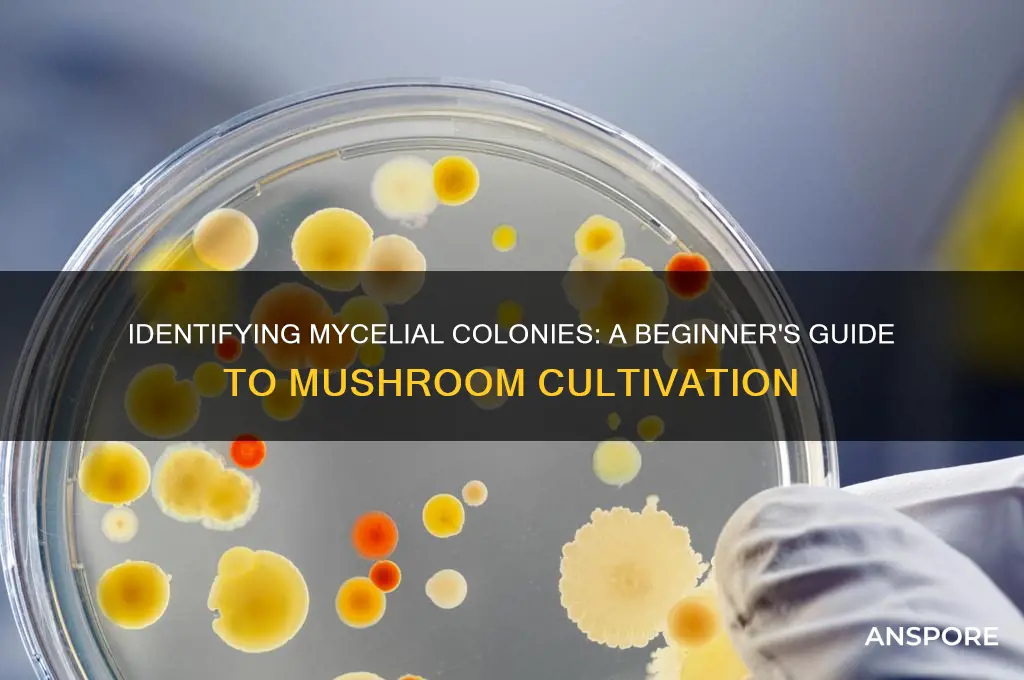
how to identify micilinial colonies for mushrooms

Identifying mycelial colonies of mushrooms is a crucial skill for both amateur mycologists and professionals, as it allows for the accurate cultivation and study of fungal species. Mycelial colonies, the vegetative part of a fungus, often appear as thread-like networks or patches on growth media, and their characteristics can vary significantly between species. Key features to observe include colony color, texture (whether it’s fluffy, cottony, or dense), growth rate, and any distinct odors. Additionally, noting the presence of rhizomorphs (root-like structures) or sporulation (the production of spores) can further aid in identification. Utilizing sterile techniques and proper agar media, such as potato dextrose agar or malt extract agar, ensures clear and uncontaminated colonies for analysis. Reference guides, taxonomic keys, and microscopy are invaluable tools for confirming species, as mycelial colonies alone may not always provide definitive identification.
Explore related products
$14.4 $18.95
What You'll Learn
- Spore color: Check underside of caps for white, pink, brown, black, or purple spores
- Gill attachment: Observe gills free, attached, or decurrent to stem for identification
- Cap texture: Note smooth, scaly, slimy, or fibrous surfaces on mushroom caps
- Stem features: Look for rings, volvas, or bulbous bases on mushroom stems
- Habitat clues: Identify trees, soil type, or decayed wood associated with colonies

Spore color: Check underside of caps for white, pink, brown, black, or purple spores
When identifying mycelial colonies of mushrooms, one of the most critical steps is examining the spore color, which can be found on the underside of the mushroom caps. Spores are the reproductive units of fungi, and their color is a key characteristic for identification. To begin, carefully turn the mushroom cap over and inspect the gill, pore, or spine structure where spores are produced. Use a magnifying glass or hand lens for a closer look, as spore colors can sometimes be subtle. The most common spore colors you’ll encounter are white, pink, brown, black, or purple, each pointing to different mushroom species or families.
White spores are among the most common and are often associated with mushrooms in the genus *Agaricus*, such as the common button mushroom. To confirm white spores, place the cap gill-side down on a dark surface, like a piece of paper or glass, and leave it undisturbed for a few hours. The spores will drop and form a distinct white print. This method, called spore printing, is essential for accurate identification. If the print is white, it narrows down the possibilities significantly, as many edible and poisonous mushrooms share this trait.
Pink spores are less common but equally important to identify. Mushrooms with pink spores often belong to the genus *Entoloma*. These spores can range from pale pink to a more vibrant shade, depending on the species. When creating a spore print, use a white surface to ensure the pink color is clearly visible. Pink-spored mushrooms are generally considered toxic, so accurate identification is crucial for foragers. Always cross-reference spore color with other characteristics to avoid misidentification.
Brown spores are widespread and found in many genera, including *Cortinarius* and *Psilocybe*. Brown spore prints can vary in shade, from light tan to dark chocolate. To distinguish brown spores, place the cap on a light-colored surface and allow the spores to drop. Brown-spored mushrooms are diverse, with some being edible and others toxic, so additional features like cap color, gill attachment, and habitat must be considered. Brown spores often indicate a mushroom that decomposes wood or leaf litter, so note the substrate where the mushroom is growing.
Black and purple spores are less common but distinctive. Mushrooms with black spores, such as those in the genus *Coprinus*, often have delicate, inky caps that dissolve over time. Purple spores are rare and typically found in species like *Lactarius deliciosus*. For both black and purple spores, use a contrasting surface for spore printing to ensure the color is accurately captured. These unique spore colors can be a quick way to narrow down the identification process, but always verify with other features to confirm the species.
In summary, examining spore color by checking the underside of mushroom caps is a fundamental step in identifying mycelial colonies. Whether you find white, pink, brown, black, or purple spores, each color provides valuable clues about the mushroom’s identity. Combine spore printing with observations of cap shape, gill structure, and habitat to make a confident identification. Always approach mushroom foraging with caution, especially when dealing with less common spore colors, and consult reliable guides or experts when in doubt.
Shaman Mushroom Spores: Legit or a Scam?
You may want to see also

Gill attachment: Observe gills free, attached, or decurrent to stem for identification
When identifying mushroom species, one of the most critical features to examine is the gill attachment to the stem. This characteristic can vary significantly and is a key diagnostic trait. Gills are the radiating, blade-like structures found under the cap of most mushrooms, and their attachment to the stem can be categorized as free, attached, or decurrent. Observing this feature carefully will help narrow down the possibilities when identifying mycelial colonies or fruiting bodies of mushrooms.
Free gills are those that do not attach to the stem at all. If you were to run your finger along the gill, it would separate cleanly from the stem without any connection. This type of gill attachment is common in species like the *Amanita* genus. When examining a mushroom, look for a clear gap between the gills and the stem. Free gills often indicate a specific group of mushrooms, so noting this feature is essential for accurate identification.
In contrast, attached gills connect directly to the stem, with no gap or separation. The gills may appear to be fused or closely adhered to the stem's surface. This attachment style is typical in many *Agaricus* species, such as the common button mushroom. When observing attached gills, you might notice that they can be notched, adnate (broadly attached), or sinuate (wavy and attached along a curve), each providing additional clues for identification.
Decurrent gills are perhaps the most distinctive, as they extend downward from the cap and run down the stem, often forming a ridge or tooth-like structure. This feature is characteristic of mushrooms in the *Paxillus* and *Gomphidius* genera. Decurrent gills can vary in how far they extend down the stem, and this detail can be crucial for differentiation. For instance, some species may have gills that only slightly touch the stem, while others may have gills running almost the entire length of the stem.
To accurately observe gill attachment, it is best to examine the mushroom from various angles, including a side view and a bottom view, where the gills meet the stem. Using a hand lens or magnifying glass can aid in seeing the finer details, especially in smaller mushroom species. Proper documentation of this feature, along with other characteristics like gill spacing, color, and cap shape, will significantly contribute to the successful identification of mushroom species.
Mushroom Coffee: Is There Really Coffee in It?
You may want to see also

Cap texture: Note smooth, scaly, slimy, or fibrous surfaces on mushroom caps
When identifying mycelial colonies of mushrooms, one of the critical features to observe is the cap texture, as it provides valuable clues about the species. The cap, or pileus, can exhibit a range of textures, including smooth, scaly, slimy, or fibrous surfaces. Smooth caps are characterized by an even, unbroken surface that feels uniform to the touch. This texture is often found in species like the common button mushroom (*Agaricus bisporus*), where the cap appears flawless and lacks any visible protrusions or irregularities. Smooth caps are typically easy to identify due to their simplicity, making them a good starting point for beginners in mushroom identification.
In contrast, scaly caps feature a surface covered in small, raised flakes or patches that resemble fish scales. These scales can vary in size and color, often contrasting with the base color of the cap. Species such as the Scaly Waxy Cap (*Hygrocybe scutellata*) exhibit this texture, which can be observed by gently running a finger over the cap to feel the distinct, raised areas. Scaly textures are particularly useful in identification, as they are less common and often specific to certain genera or species.
Slime-covered caps are another texture to note, where the surface appears glossy or wet due to a mucilaginous layer. This slime can be clear, opaque, or tinted, and it often serves to protect the mushroom from drying out or deter predators. Species like the Slime-coated Mushroom (*Limacella delicata*) are prime examples of this texture. To identify slime, look for a shiny or sticky surface, and avoid touching it excessively, as the slime can be easily removed. This texture is particularly distinctive and can narrow down the possibilities when identifying mushrooms.
Fibrous caps are characterized by a surface that appears thread-like or stringy, often with visible strands or fibers running across the cap. This texture is common in species such as the Shaggy Mane (*Coprinus comatus*), where the cap’s surface breaks up into scales or fibers as the mushroom matures. Fibrous textures can be felt by gently pressing or stroking the cap, revealing the coarse, hair-like structure. This texture is not only tactile but also visually striking, making it a key feature in identification.
Lastly, it’s important to observe how the cap texture interacts with other features, such as color, shape, and margin characteristics. For instance, a smooth cap might also have a striated margin, while a scaly cap could have a convex shape. Combining observations of texture with other traits will enhance accuracy in identifying mycelial colonies and their corresponding mushroom species. Always use a magnifying lens or microscope for detailed examination, as subtle textures can be crucial in distinguishing between similar species.
Shiitake Mushrooms: Sugar Content and Nutritional Facts
You may want to see also
Explore related products

Stem features: Look for rings, volvas, or bulbous bases on mushroom stems
When identifying mushroom species, examining the stem features is a crucial step, as structures like rings, volvas, and bulbous bases can provide key diagnostic characteristics. Rings on mushroom stems, also known as annuli, are remnants of the partial veil that once connected the cap to the stem. As the mushroom matures and the cap expands, the partial veil breaks, leaving behind a ring-like structure. This feature is commonly found in genera such as *Amanita* and *Marasmius*. To identify a ring, carefully inspect the upper to middle portion of the stem for a skirt-like or collar-like structure. Its presence, texture, and persistence can help narrow down the species.
Another important stem feature is the volva, a cup-like structure at the base of the stem, formed from the universal veil that encases the young mushroom. Volvas are most notably associated with the genus *Amanita*, including both edible species like the Caesar's mushroom (*Amanita caesarea*) and highly toxic ones like the death cap (*Amanita phalloides*). When searching for a volva, gently dig around the base of the mushroom to expose the soil-covered stem. Carefully brush away the soil to reveal any cup-like or sheathing structures. The presence of a volva is a significant identifier but always consider other features to avoid misidentification.
Bulbous bases are another stem characteristic to look for, where the stem widens significantly at the base, often forming a distinct bulb. This feature is common in species like the poisonous *Amanita ocreata* and some *Leucocoprinus* species. When examining a bulbous base, note its shape, margin (whether it is abrupt or gradual), and any additional features like rhizomorphs or rooting structures. Bulbous bases can sometimes be hidden beneath the soil, so carefully excavating the base of the mushroom is essential for accurate identification.
In summary, when identifying mushroom species, pay close attention to stem features such as rings, volvas, and bulbous bases. Rings indicate the presence of a partial veil, volvas suggest a universal veil, and bulbous bases provide clues about the mushroom's growth structure. Each of these features, when observed carefully, can significantly aid in distinguishing between similar-looking species. Always combine these observations with other characteristics like cap color, gill attachment, and spore print for a comprehensive identification.
Mushroom Rings: Nature's Magical Mystery
You may want to see also

Habitat clues: Identify trees, soil type, or decayed wood associated with colonies
When identifying mycelial colonies of mushrooms, understanding their habitat is crucial. Mushrooms often form symbiotic relationships with specific tree species, so identifying the trees in the area can provide valuable clues. For example, mycorrhizal fungi, which form mutualistic associations with tree roots, are commonly found near certain tree species like oak, beech, pine, or birch. Observe the dominant tree types in the vicinity of the colony. Deciduous forests, especially those with mature trees, are hotspots for species like chanterelles and porcini, while coniferous forests often host boletes and lactarius. Note the health and age of the trees, as some fungi prefer living trees, while others thrive on stressed or decaying ones.
Soil type is another critical habitat clue for identifying mycelial colonies. Different mushrooms have specific soil preferences based on pH, moisture, and nutrient content. For instance, morel mushrooms often grow in disturbed soils, such as those found in recently burned areas or riverbanks, which are typically rich in minerals. On the other hand, truffles prefer calcareous soils with a higher pH. Look for signs of soil composition, such as the presence of limestone, sand, or clay. Moisture levels are also key; some fungi, like shiitake, thrive in well-drained, woody soils, while others, like oyster mushrooms, prefer damp, decaying environments.
Decayed wood is a telltale sign of certain mycelial colonies, as many mushrooms are saprotrophic, meaning they decompose dead organic matter. Identify whether the colony is growing directly on fallen logs, stumps, or branches. For example, reishi mushrooms are often found on decaying hardwoods like maple or oak, while turkey tail fungi colonize a wide range of decaying wood. Inspect the type of wood—coniferous or deciduous—as this can narrow down the species. The stage of decay also matters; some fungi prefer freshly fallen wood, while others colonize well-rotted logs.
The arrangement and density of trees, soil characteristics, and decayed wood can further refine your identification. Mycelial colonies often spread in patterns influenced by their habitat. For instance, fairy rings appear in grassy areas where the mycelium has depleted nutrients in the center, forcing the fungus to grow outward. In forested areas, clusters of mushrooms may indicate a network of mycelium beneath the soil or wood. Pay attention to microhabitats, such as north-facing slopes, which retain moisture longer and may host different species than south-facing slopes.
Lastly, consider the broader ecosystem and seasonal factors. Some mushrooms are more prevalent in specific seasons due to temperature and moisture conditions. For example, spring mushrooms like morels often appear after the first warm rains, while fall is prime time for species like lion's mane and hen of the woods. Documenting these habitat clues—tree species, soil type, decayed wood, and environmental conditions—will significantly enhance your ability to identify mycelial colonies accurately. Always cross-reference these observations with other identification methods, such as spore prints or gill structure, for a comprehensive analysis.
Summoning the Mushroom NPC: A Step-by-Step Guide
You may want to see also
Frequently asked questions
Key characteristics include colony color, texture (e.g., fluffy, cottony, or dense), growth rate, and the presence of rhizomorphs or aerial hyphae. Additionally, note any distinct odors, such as earthy or fruity scents, which can be species-specific.
The color of the mycelium can vary widely between species. For example, *Pleurotus* (oyster mushrooms) often have white to cream-colored mycelium, while *Lentinula edodes* (shiitake) may have brown or tan mycelium. Color is a critical visual cue for identification.
Yes, texture is a useful identifier. Some species, like *Agaricus*, produce dense, compact mycelium, while others, such as *Trametes*, may have a more fibrous or stringy texture. Observing whether the mycelium is fluffy, cottony, or granular can narrow down the possibilities.
The growth pattern, such as radial, circular, or diffuse, can help distinguish species. For instance, *Ganoderma* often forms thick, fan-shaped colonies, while *Mycelium* of *Stropharia* may grow more uniformly. Growth rate and density also provide clues to the species.

























